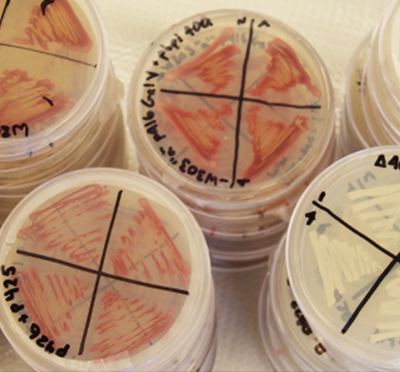

Duennwald Lab
The Duennwald lab explores the role of protein misfolding, aging, and cellular quality control in human diseases, focusing on age-related neurodegenerative diseases, such as Parkinson’s disease, Huntington’s disease, and ALS. Neurodegenerative diseases presently afflict 700,000 Canadians creating tremendous personal, social, and financial hardship, and the number of patients is projected to double over the next 20 years. Yet, there is no effective therapeutic approach to treat neurodegenerative diseases. Our research employs innovative experimental approaches to identify new therapeutic strategies for the treatment of neurodegenerative diseases.
Learn more
Our Research
For specific projects, please visit the research page.
Contact Us
Schulich School of Medicine & Dentistry,
404 Medical Sciences Building
London, Ontario, Canada
